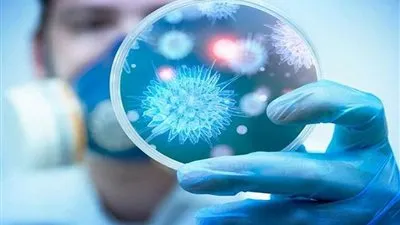
دون وفيات.. الصين تسجل إصابة واحدة بكورونا

عاجل
الجزائر في اختبار صعب أمام الكونغو الديمقراطية.. من سينجو ويبلغ دور الثمانية؟
الجزائر والكونغو الديمقراطية في مواجهة نارية.. من سينتزع بطاقة دور الثمانية؟
بث مباشر | الجزائر تواجه الكونغو الديمقراطية في ثمن نهائي كأس الأمم الأفريقية 2026
بث مباشر | الجزائر في صدام قوي أمام الكونغو الديمقراطية بحثًا عن تأشيرة دور الثمانية
شجع المنتخب بث مباشر،:⛹️📺🔥 3 قنوات غير مشفرة تنقل «ماتش» مباراة مصر، 🇪🇬 ضد بنين، 🇧🇯 | Egypt vs Benin في كأس الأمم الأفريقية 2025 ⚽️🏆